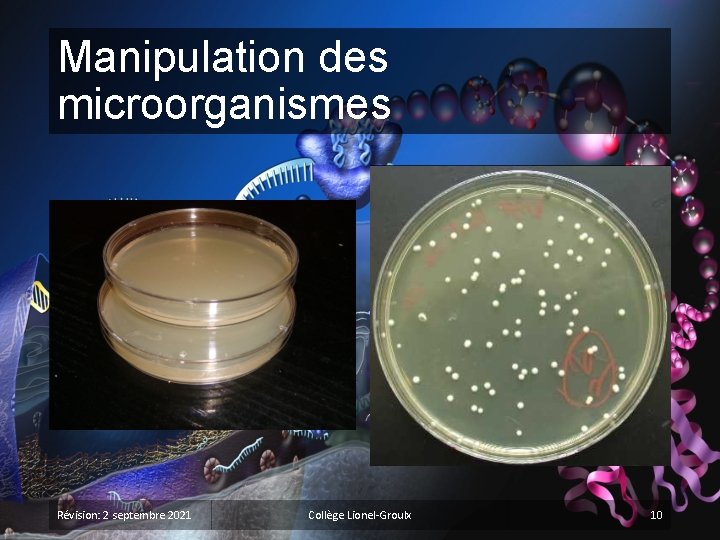
Manipulation des microorganismes Révision: 2 septembre 2021 Collège Lionel-Groulx 10

La transformation bactrienne Bactries ou mduses le code

La transformation bactérienne Bactéries ou méduses, le code génétique est universel!

Plan du cours § Qu’est-ce qu’un plasmide? § La transformation: animation et application § Laboratoire « Transformation bactérienne » § Travailler en asepsie § Utilisation des micropipettes § Manipulations du labo Révision: 2 septembre 2021 Collège Lionel-Groulx 2

Les plasmides § Molécules d’ADN circulaires § Ne contiennent quelques gènes (très petits) § Seulement quelques bactéries en possèdent § Peuvent être manipulés en génie génétique 5400 bp? ori? ara. C? GFP? Amp? Révision: 2 septembre 2021 Collège Lionel-Groulx 3

Qu’est-ce qu’un plasmide? Révision: 2 septembre 2021 Collège Lionel-Groulx 4

Qu’est-ce que la transformation bactérienne? § Modification des caractéristiques d’une bactérie par l’absorption d’un ADN étranger présent dans le milieu. Révision: 2 septembre 2021 Collège Lionel-Groulx 5

Transformation bactérienne à l’aide d’un plasmide Animation 1 (anglais) Animation 2 (anglais)

Le clonage génétique à l’aide d’un plasmide: applications en biotechnologie Révision: 2 septembre 2021 Collège Lionel-Groulx 7

Les concepts-clés du labo § ADN, gènes et plasmides § Transformation bactérienne § Régulation de la transcription § Transcription et traduction § Expression génique § Mode d’action des antibiotiques § Antibiorésistance Révision: 2 septembre 2021 Collège Lionel-Groulx 8

Manipulation des microorganismes § Les microorganismes sont prélevés de leur milieu de croissance § Avec des écouvillons (milieu solide) § Avec une micropipette (milieu liquide) § Travail en asepsie § S’assurer qu’aucune contamination externe n’est possible § Exemples: lavage de mains, stérilisation des instruments, ouverture des pétris, travail près d’une flamme… Révision: 2 septembre 2021 Collège Lionel-Groulx 9
Manipulation des microorganismes Révision: 2 septembre 2021 Collège Lionel-Groulx 10

Au travail!
- Slides: 11